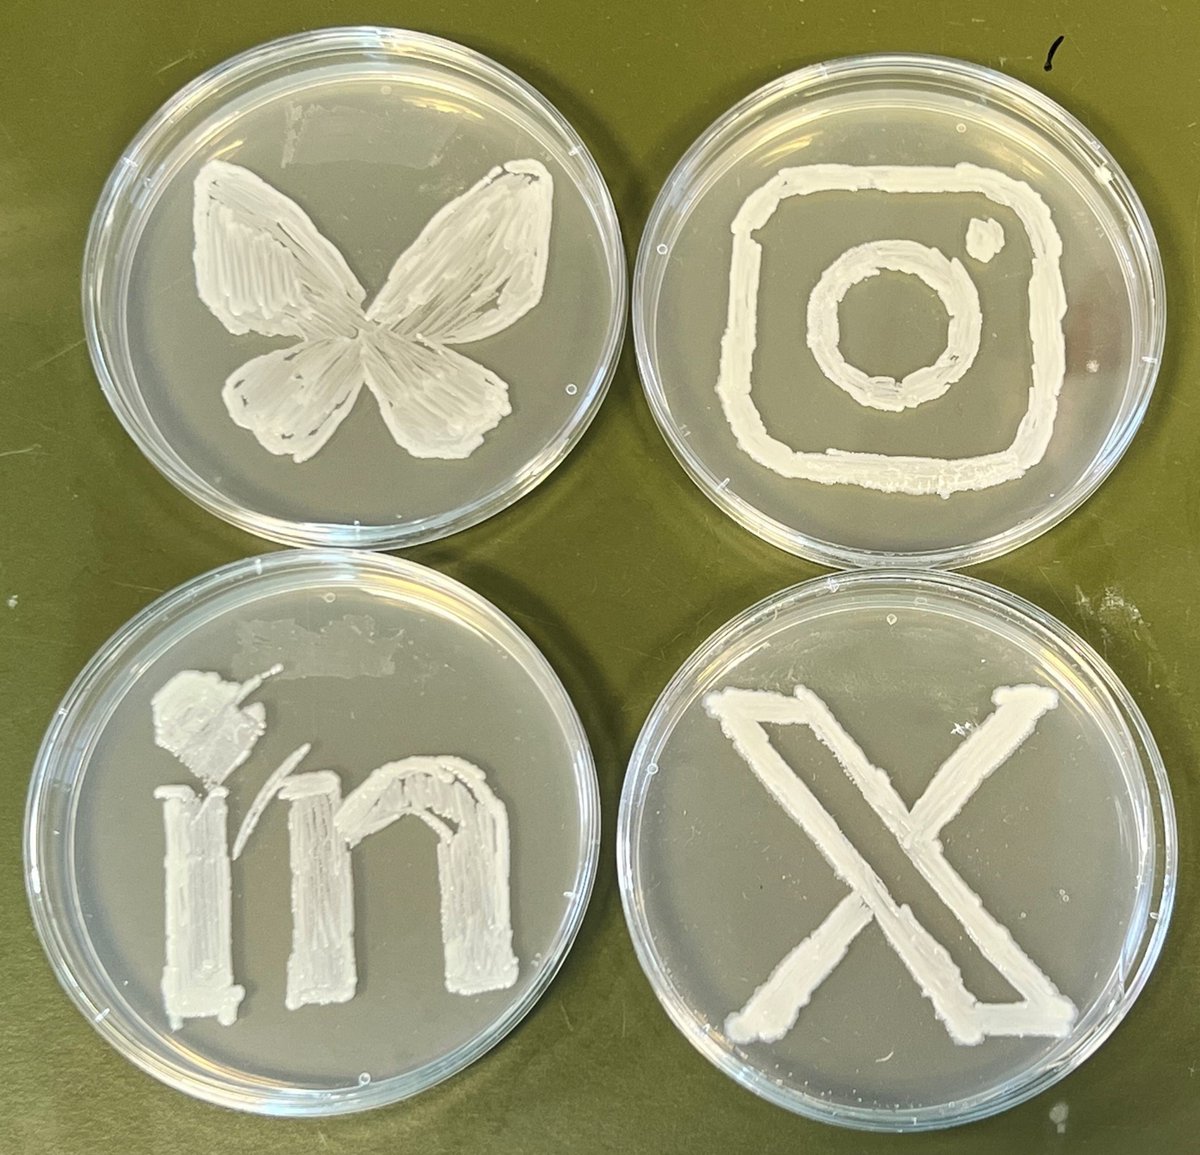

BCCM Collections
@bccmcollections
7 decentralised biological resource centres with complementary expertise, providing over 316.000 strains of bacteria, fungi, diatoms, cyanobacteria and plasmids
ID: 1095237930908614656
http://bccm.belspo.be 12-02-2019 08:27:26
645 Tweet
392 Takipçi
231 Takip Edilen

Arthroderma vanbreuseghemii sp. nov. In honor of Prof. Vanbreuseghem for his great contribution to medical mycology. He's the founder of the RV collection initiated in Paris (1947), developed Institute of Tropical Medicine Antwerp & transferred to BCCM/IHEM (1997) IHEM 3299 #fungi #microbiology Belspo




Studying the evolution of 'basal' cyanobacteria? This BCCM/ULC Christmas offer is for you! Get FREE state-of-the-art genomic services in return for depositing your basal unicyanobacterial strain(s) during 2025. Conditions: bccm.belspo.be/images/ulc/off… Contact: [email protected]